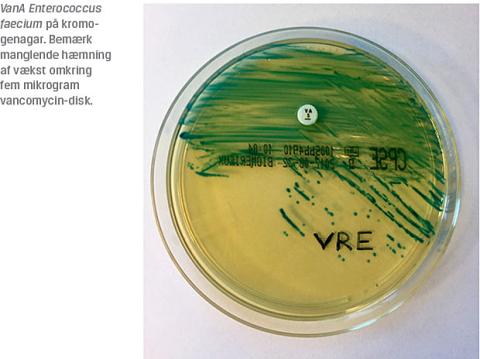

Vancomycinresistente enterokokker (VRE) er et hastigt voksende problem på de danske hospitaler. Antallet af patienter, hos hvem man har fundet VRE i kliniske prøver, er mere end ottedoblet i perioden 2012-2016 [1]. Incidensen steg drastisk i 2013, og stigningen er fortsat siden da [2] til 434 tilfælde i 2016. Infektioner med VRE medfører større mortalitet, længere indlæggelsesvarighed og øget risiko for recidiv end infektioner med vancomycinfølsomme enterokokker. Fund af VRE medfører langvarig isolation, hvilket kan forsinke udredningen og bidrage til de i forvejen øgede økonomiske omkostninger pr. indlæggelse [3]. Enterokokker er naturligt resistente over for mange antibiotikagrupper, de er nedsat følsomme over for penicillin, resistente over for cefalosporiner og lavresistente over for aminoglykosider. Ampicillin er førstevalg til behandling af enterokokinfektioner, hvis isolatet er følsomt for stoffet, men ampicillinresistens er efterhånden meget udbredt.
I 2016 var 91,5% af danske Enterococcus faecium-bloddyrkningsisolater resistente [1]. Vancomycin er hjørnestenen i behandling af ampicillinresistente enterokokker, og derfor er behandlingsmulighederne yderst begrænsede, hvis bakterierne er blevet vancomycinresistente. Vi vil i denne artikel give et overblik over behandlingsmuligheder ved infektioner med VRE med vægt på ampicillin- og vancomycinresistente E. faecium, som er den dominerende type VRE i Danmark.

GENERELT OM ENTEROKOKKER
Enterokokker er grampositive diplokokker, som har deres naturlige reservoir i tarmen. Der findes mere end 50 arter, men E. faecalis og E. faecium er de klinisk mest relevante. E. faecalis er mere virulent end E. faecium og er en hyppig årsag til samfundserhvervede urinvejsinfektioner (UVI), abdominale infektioner og infektiøs endokarditis. Den kan også være årsag til nosokomielle infektioner, hvor der ud over de ovennævnte foci ses fremmedlegemeassocierede infektioner som infektion ved et centralt venekateter (CVK) eller en ledprotese [4]. E. faecium ses først og fremmest ved nosokomielle infektioner hos i forvejen svækkede patienter. Der er tale om de samme foci, som nævnt for E. faecalis. Infektiøs endokarditis med E. faecium ses dog sjældent [4].
ANTIBIOTIKARESISTENS HOS ENTEROKOKKER
Enterokokker er naturligt nedsat følsomme over for
penicillin og aminoglykosider, mens de er ampicillinfølsomme. Som regel har E. faecium dog erhvervet
resistens over for ampicillin [1]. Både E. faecalis og
E. faecium er naturligt følsomme over for vancomycin, men kan erhverve resistens over for dette antibiotikum.
Resistens formidles af såkaldte van-gener, der ændrer peptidoglykanens aminosyresammensætning, hvilket nedsætter vancomycins affinitet over for molekylet [5]. Erhvervede van-gener ligger typisk på mobile genetiske elementer, transposoner og plasmider, hvilket gør horisontal genoverførsel mulig [6].
ANTIBIOTISK BEHANDLING AF INFEKTIONER FORÅRSAGET AF VANCOMYCINRESISTENTE
ENTEROKOKKKER
Indikationsstilling for antibiotisk behandling
Når VRE bliver fundet i screeningsprøver (rektalpodning), er det udtryk for bærertilstand og ikke indikation for antibiotisk behandling. I kliniske prøver bliver VRE hyppigst isoleret fra urinvejene, men kun en lille del af dem skyldes en klinisk betydende urinvejsinfektion, som kræver antibiotisk behandling [7]. Fund af VRE i kliniske prøver kræver altid en kritisk vurdering af fundets kliniske betydning. F.eks. kan fund af VRE i prøver fra perkutane dræn være udtryk for drænkolonisering snarere end behandlingskrævende infektion. Andre behandlingsbehov end antibiotika, f.eks. kirurgisk fokussanering, bør ligeledes vurderes.
UKOMPLICERET URINVEJSINFEKTION
En ukompliceret cystitis, hvor der ved mikrobiologisk prøvetagning er påvist ampicillinresistente VRE, skal fortrinsvis behandles, når der foreligger mikrobiologisk resistensbestemmelse. Behandlingsmulighederne er følgende:
Ciprofloxacin
Ciprofloxacin tilhører stofgruppen af fluorquinolonerne og bruges i Danmark kun som andetvalg til
behandling af ukomplicerede urinvejsinfektioner.
Det bruges traditionelt ikke til behandling af enterokokker. Den europæiske komité for resistensbestemmelse, EUCAST, har i 2014 udgivet retningslinjer til resistensbestemmelse af enterokokker ved ukomplicerede urinvejsinfektioner [8], hvori man tager højde for stoffets høje koncentration i urinen. Der er kun få studier, hvor man har dokumenteret den kliniske effekt af denne behandling. Disse omhandler udelukkende
E. faecalis og ikke E. faecium [9].
Nitrofurantoin
Efter peroral indtagelse bliver nitrofurantoin hurtigt udskilt via nyrerne og opnår derfor kun lave serum-, men høje urinkoncentrationer. Dermed er det ikke
egnet til patienter med nedsat nyrefunktion. Nitrofurantoin er tidligere blevet anbefalet til behandling af ukompliceret UVI med VRE [10, 11]. I EUCAST anbefaler man ikke at resistensbestemme E. faecium over for nitrofurantoin [8]. Dette skyldes, at nitrofurantoins
minimale inhibitoriske koncentration for E. faecium er høj, og den kliniske effekt usikker. Nitrofurantoinbehandling kan forsøges, men den kliniske effekt må følges nøje, da effekten af denne behandling ved cystitis udløst af VRE kun er beskrevet kasuistisk [12].
ANBEFALINGER
Ved fund af ampicillinfølsomme VRE er ampicillin førstevalg, men ampicillin vil i praksis sjældent kunne anvendes grundet den høje forekomst af resistens blandt VRE. Ved ampicillinresistens anbefales behandling med ciprofloxacin, da der foreligger bedre dokumentation for ciprofloxacins end for nitrofurantoins effekt på
E. faecium [9]. Er behandling med ciprofloxacin ikke en mulighed, kan behandling med nitrofurantoin forsøges. Internationalt anbefales også behandling med peroralt givet fosfomycin [10, 13], men dette antibiotikum er ikke tilgængeligt i Danmark. Resistens over for ciprofloxacin og nitrofurantoin er udbredt blandt VRE, således at behandlingen kun kan iværksættes, hvis isolatet ved resistensbestemmelse er fundet følsomt over for stoffet. Hvis resistensbestemmelsen tyder på, at isolatet hverken er ciprofloxacin- eller nitrofurantoinfølsomt, kan der behandles med linezolid eller daptomycin. Daptomycin udskilles i højere grad end linezolid i urinen, og hvis intravenøs behandling er en mulighed, er daptomycin at foretrække. Peroralt givet linezolid kan anvendes, hvis intravenøs behandling ikke er mulig.
BAKTERIÆMI OG ANDRE ALVORLIGE INFEKTIONER
De i Danmark tilgængelige antibiotika til behandling af alvorlige VRE-infektioner er følgende (Tabel 1):

Linezolid
Linezolid er et oxazolidinonantibiotikum, som virker bakteriostatisk på grampositive bakterier ved at hæmme proteinsyntesen. Linezolidbehandling kan resultere i knoglemarvsdepression, hvorfor der anbefales ugentlig kontrol af blodbilledet ved brug af stoffet. Der mangler kliniske studier af behandlingsvarighed i over 28 dage, hvorfor dette anbefales som den maksimale behandlingsvarighed [14]. Resistensudvikling over for linezolid er beskrevet i Danmark [1]. Linezolid har god penetration til centralnervesystemet (CNS) og er blevet brugt til behandling af CNS-infektioner med VRE [11, 13].
Daptomycin
Daptomycin er et lipopeptidantibiotikum, som virker baktericidt på grampositive bakterier ved at svække den bakterielle cellevæg. Det er kun tilgængeligt som infusionsvæske og doseres afhængigt af indikation. Den indregistrerede dosering til behandling af Staphylococcus aureus-bakteriæmi er 6 mg/kg. I tidligere behandlingsstudier af VRE har man ofte anvendt denne dosis. Daptomycin kan udløse rabdomyolyse [15]. Derfor
anbefales kontrol af kreatinkinaseniveauet, inden behandlingen påbegyndes, og ugentlig kontrol under
behandlingsforløbet samt forsigtighed ved samtidig statinbehandling. Både in vitro-data og nye kliniske studier støtter højere dosering (8-12 mg/kg) til behandling af enterokokinfektioner [16, 17]. Disse studier viste, at højdosisbehandling ikke bevirkede hyppigere forhøjelse af kreatinkinaseniveauet [16, 18, 19], og denne bivirkning gav ikke anledning til skift af behandling [18]. Især et nyligt publiceret, stort, retrospektivt kohortestudie fra USA skal fremhæves, idet man her fandt en nedsat mortalitet ved behandling
af VRE-bakteriæmi med daptomycin i en dosering på
≥ 10 mg/kg i stedet for den tidligere anvendte dosering på < 10 mg/kg [16]. For nuværende anbefales dosering på ≥ 10 mg/kg, som er højere end den indregistrerede dosis ved alvorlige enterokokinfektioner. Daptomycin inaktiveres af surfaktant i lungevævet og er således uegnet til behandling af pulmonale infektioner. De novo resistensudvikling under igangværende behandling med daptomycin er beskrevet [20, 21].
Tigecyclin
Tigecyclin er et glycylcyclinantibiotikum og et derivat af tetracyclin. Tigecyclin virker bakteriostatisk ved at hæmme bakteriernes proteinsyntese igennem inhibition af den ribosomale 30S-subunit. Tigecyclin har, ligesom tetracycliner, en god vævspenetration. Dette er en fordel ved behandling af komplicerede intraabdominale infektioner og bløddelsinfektioner [22]. Tigecyclin frarådes til behandling af bakteriæmi, da der kun opnås lave serumkoncentrationer [23], og stoffet anbefales ikke som monoterapi til VRE-behandling.
ANBEFALINGER
Valget af behandling ved VRE-bakteriæmi afhænger af den kliniske tilstand og det formodede infektionsfokus. Få antibiotika med effekt på VRE er tilgængelige og de novo-resistensudvikling er beskrevet for de to vigtigste [20, 21]: linezolid og daptomycin. Derfor bør kombinationsbehandling altid overvejes. I internationale retningslinjer anbefaler man ikke kategorisk kombinationsbehandling [11, 13, 24], og ved bakteriæmi med ukompliceret fokus kan antibiotisk monoterapi være tilstrækkelig. Eksempler på dette er bakteriæmi med udgangspunkt i et inficeret CVK eller et kateter à demeure, som er fjernet. De bedst undersøgte antibiotika til monoterapi ved VRE-bakteriæmi er linezolid og daptomycin (Tabel 2). Der foreligger fire metaanalyser [25-28], hvor man har sammenlignet effekten af daptomycin og linezolid til behandling af VRE-bakteriæmi. I metaanalyserne indgår der kun retrospektive studier med betydelig variation i dosering af daptomycin. I de første tre metaanalyser [25-27] fandt man en lavere mortalitet ved behandling med linezolid end ved behandling med daptomycin [26, 27] eller en tendens mod dette [25].
I den nyeste metaanalyse fandt man ingen signifikant forskel [28]. I sidstnævnte er der udelukkende inkluderet studier med daptomycindosis på ≥ 6 mg/kg legemsvægt, og derudover er der inkluderet det hidtil største retrospektive kohortestudie, hvor man fandt en signifikant reduceret mortalitet ved behandling med daptomycin [29].

For nuværende må det derfor konkluderes, at der ikke kan gives en klar anbefaling om at foretrække enten linezolid eller daptomycin som førstevalgsbehandling.
Ved et kompliceret fokus eller påkrævet længerevarende antibiotisk behandling foreslås kombinationsbehandling. Eksempler på komplicerede infektioner er
intraabdominale infektioner, knogle- og ledproteseinfektioner samt infektiøs endokarditis. Klinisk praksis i Danmark er at behandle alvorlige VRE-infektioner med både linezolid og daptomycin, men afhængig af fokus og resistensbestemmelse kan forskellige kombinationer komme på tale (Figur 1). Der består stadigvæk et stort behov for afklarende studier mhp. valg af antibiotika til komplicerede infektioner med VRE. Nyere studier [29] tyder på, at daptomycin kunne være at foretrække frem for linezolid. In vitro-forsøg har vist en synergistisk effekt ved kombination af daptomycin med betalaktamantibiotika [21]. Allerede i dag nævnes dette regime ved behandling af VRE-endokarditis [30], men kliniske studier savnes.

KONKLUSION
VRE er et hastigt voksende problem i Danmark og internationalt. Anbefalinger til antibiotisk behandling bygger på retrospektive studier, caseserier og klinisk erfaring. Vi præsenterer i denne artikel et forslag til behandlingsanbefalinger ved VRE-infektioner. Til behandling af ukompliceret cystitis anbefales ciprofloxacin eller nitrofurantoin, såfremt isolatet er følsomt. Hjørnestenen til behandling af alvorlige infektioner er linezolid og højdosis daptomycin. Samtidig anbefales kontakt til den lokale mikrobiologiske afdeling om valg af behandling.
KORRESPONDANCE: Lars Christian Lund. Email: lcl@posteo.dk
ANTAGET: 6. december 2017
PUBLICERET PÅ UGESKRIFTET.DK: 16. april 2018
INTERESSEKONFLIKTER:
LITTERATUR
-
DANMAP 2016 – use of antimicrobial agents and occurrence of antimicrobial resistance in bacteria from food animals, food and humans in Denmark. www.danmap.org (25. nov 2017).
-
Hammerum AM, Baig S, Kamel Y et al. Emergence of vanA Enterococcus faecium in Denmark, 2005-15. J Antimicrob Chemother 2017;72:
2184-90. -
Chiang H-Y, Perencevich EN, Nair R et al. Incidence and outcomes associated with infections caused by vancomycin-resistant enterococci in the United States: systematic literature review and meta-analysis. Infect Control Amp Hosp Epidemiol 2017;38:203-15.
-
Pinholt M, Østergaard C, Arpi M et al. Incidence, clinical characteristics and 30-day mortality of enterococcal bacteraemia in Denmark 2006-2009: a population-based cohort study. Clin Microbiol Infect 2014;
20:145-51. -
Faron ML, Ledeboer NA, Buchan BW. Resistance mechanisms, epidemiology, and approaches to screening for vancomycin-resistant enterococcus in the health care setting. J Clin Microbiol 2016;54:2436-47.
-
Arthur M, Courvalin P. Genetics and mechanisms of glycopeptide resistance in enterococci. Antimicrob Agents Chemother 1993;37:
1563-71. -
Wong AH, Wenzel RP, Edmond MB. Epidemiology of bacteriuria caused by vancomycin-resistant enterococci – a retrospective study. Am J
Infect Control 2000;28:277-81. -
The European Committee on Antimicrobial Susceptibility Testing. Breakpoint tables for interpretation of MICs and zone diameters, version 7.1. www.eucast.org/fileadmin/src/media/PDFs/EUCAST_files/Breakpoint_tables/… (8. jul 2017).
-
Ekelund O, Kahlmeter G. Is there a role for the fluoroquinolones in the treatment of enterococcal urinary tract infections? www.eucast.org/fileadmin/src/media/PDFs/EUCAST_files/Consultation/FQ_an… (7. jul 2017).
-
Heintz BH, Halilovic J, Christensen CL. Vancomycin-resistant enterococcal urinary tract infections. Pharmacother J Hum Pharmacol Drug Ther 2010;30:1136-49.
-
Arias CA, Contreras GA, Murray BE. Management of multidrug-resistant enterococcal infections. Clin Microbiol Infect 2010;16:555-62.
-
Panesso D, Ospina S, Robledo J et al. First characterization of a cluster of VanA-type glycopeptide-resistant Enterococcus faecium, Colombia. Emerg Infect Dis 2002;8:961-5.
-
O’Driscoll T, Crank CW. Vancomycin-resistant enterococcal infections: epidemiology, clinical manifestations, and optimal management. Infect Drug Resist 2015;8:217-30.
-
French G. Safety and tolerability of linezolid. J Antimicrob Chemother 2003;51:45ii-53ii.
-
Papadopoulos S, Ball AM, Liewer SE et al. Rhabdomyolysis during therapy with daptomycin. Clin Infect Dis 2006;42:e108-e110.
-
Britt NS, Potter EM, Patel N et al. Comparative effectiveness and safety of standard-, medium-, and high-dose daptomycin strategies for the treatment of vancomycin-resistant enterococcal bacteremia among veterans affairs patients. Clin Infect Dis 2017;64:605-13.
-
European Committee on Antimicrobial Susceptibility Testing. Guidance document on use of daptomycin to treat enterococcal endocarditis. www.eucast.org/fileadmin/src/media/PDFs/EUCAST_files/General_
documents/EUCAST_daptomycin_guidance_note_20160924.pdf (8. jul 2017). -
Casapao AM, Kullar R, Davis SL et al. Multicenter study of high-dose daptomycin for treatment of enterococcal infections. Antimicrob Agents Chemother 2013;57:4190-6.
-
Kullar R, Davis SL, Levine DP et al. High-dose daptomycin for treatment of complicated gram-positive infections: a large, multicenter, retrospective study. Pharmacotherapy 2011;31:527-36.
-
Egli A, Schmid H, Kuenzli E et al. Association of daptomycin use with resistance development in Enterococcus faecium bacteraemia – a 7-year individual and population-based analysis. Clin Microbiol Infect 2017;23:118.e1-118.e7.
-
Munita JM, Murray BE, Arias CA. Daptomycin for the treatment of bacteraemia due to vancomycin-resistant enterococci. Int J Antimicrob Agents 2014;44:387-95.
-
Scheetz MH, Reddy P, Nicolau DP et al. Peritoneal fluid penetration of tigecycline. Ann Pharmacother 2006;40:2064-7.
-
Meagher AK, Ambrose PG, Grasela TH et al. The pharmacokinetic and pharmacodynamic profile of tigecycline. Clin Infect Dis 2005;41:S333-S340.
-
Mutters NT, Werner G, Tacconelli E et al. Vancomycin-resistente Enterokokken: welche Therapieoptionen gibt es? Dtsch Med Wochenschr 2015;140:42-5.
-
Whang DW, Miller LG, Partain NM et al. Systematic review and meta-analysis of linezolid and daptomycin for treatment of vancomycin-
resistant enterococcal bloodstream infections. Antimicrob Agents Chemother 2013;57:5013-8. -
Balli EP, Venetis CA, Miyakis S. Systematic review and meta-analysis of linezolid versus daptomycin for treatment of vancomycin-resistant enterococcal bacteremia. Antimicrob Agents Chemother 2014;58:
734-9. -
Chuang Y-C, Wang J-T, Lin H-Y et al. Daptomycin versus linezolid for treatment of vancomycin-resistant enterococcal bacteremia: systematic review and meta-analysis. BMC Infect Dis 2014;14:687.
-
Zhao M, Liang L, Ji L et al. Similar efficacy and safety of daptomycin versus linezolid for treatment of vancomycin-resistant enterococcal bloodstream infections: a meta-analysis. Int J Antimicrob Agents 2016;48:231-8.
-
Britt NS, Potter EM, Patel N et al. Comparison of the effectiveness and safety of linezolid and daptomycin in vancomycin-resistant enterococcal bloodstream infection: a national cohort study of veterans affairs patients. Clin Infect Dis 2015;61:871-8.
-
Baddour LM, Wilson WR, Bayer AS et al. Infective endocarditis in adults: diagnosis, antimicrobial therapy, and management of complications: a scientific statement for healthcare professionals from the American Heart Association. Circulation 2015;132:1435-86.
Vancomycin-resistant enterococci (VRE) are a growing healthcare concern, and since 2012 the incidence has increased eightfold in Denmark. Treatment options for infections with ampicillin-resistant VRE are sparse, and there are no Danish guidelines concerning this topic. For treatment of uncomplicated VRE urinary tract infections, ciprofloxacin or nitrofurantoin can be used. The mainstay of treatment of bacteraemia and other severe infections caused by VRE is linezolid or high-dose daptomycin. Combination treatment is recommended for complicated infections and/or prolonged therapy.